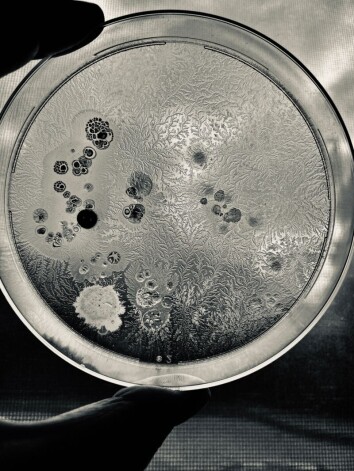

Фотография кормящихся муравьев получила приз Королевского биологического общества
Вишванат Бирдже стал победителем фотоконкурса Королевского биологического общества за фотографию муравьев, питающихся медвяной падью, выделяемой желтой тлей.
Бирдже, сделавший свой снимок в Индии, сказал: "В природе вокруг нас происходит много волшебных событий - а я просто любопытный и наблюдательный". В ежегодном фотоконкурсе Королевского биологического общества участвуют фотографы-любители со всего мира. В этом году тема конкурса - "Взаимосвязь", в нем участвовало более 1600 работ, пишет BBC.

Второе место: Труонг Хоай Ву - морская экосистема Хон Йен, Фу Йен, Вьетнам
Каждый год с мая по август кораллы этой богатой и разнообразной экосистемы обнажаются во время отлива.
Шорт-лист
"Семейная ссора" - Альфонсо Рольдан Лосада, Кордова, Испания

Щурки на ветке. Эту гнездящуюся в Южной Европе птицу легко узнать благодаря ярко окрашенным перьям
"Чума" - Генри Харт, Борана, Кения

В 2019 году Кения и большая часть Восточной Африки пострадали от самого масштабного за 70 лет нашествия саранчи
"Охота" - Рипан Бисвас, Западная Бенгалия, Индия

Нападение осы на таракана
"Укус на выживание" - Вэй Фу, Бангкок, Таиланд

Токайский геккон и древесная змея
"Человек-паук нашего тела" - Чанчал Сур Чоудхури, Миссури, США

Клетки нейтрофилов (светло-голубые) выделяют сетчатые структуры (желтые) для защиты от бактерий туберкулеза (розовый)
"Небольшое собрание" - Джон Ишид Буланади, Пампанга, Филиппины

Небольшая группа муравьев собирается полакомиться несколькими каплями сиропа на яблочном листе
"Подзарядка солнечной энергией" - Гу Гуанхуй, провинция Чжэцзян, Китай

Большая группа цапель расселась на солнечных панелях в сумерках
Молодой фотограф года: Роан Джонс, Сомерсет, Великобритания

Победителем конкурса "Молодой фотограф года" Королевского биологического общества стал 15-летний Роан Джонс. Он запечатлел шину, которую поглощает природа в лесу Валлис, Сомерсет, показывая связь между людьми и миром природы. "Мне захотелось сделать снимок в лесу рядом с моим родным городом, потому что я часто тут бываю и знаю, что здесь масса всего интересного", - сказал он.
Второе место: Элис Фэн, Великобритания
Это бактерии Bacillus subtilis, выращенные в лабораторной чашке с питательной средой. Эти "узоры" - фрактальное распределение бактерий - формируются в зависимости от условий окружающей среды и того, как бактериальные клетки перемещаются после контакта друг с другом.
Специальный приз: "Водопой" - Хайден Вуд, Кения

Зебры на водопое